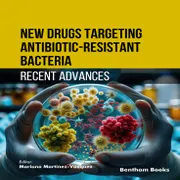

Leg jetzt kostenlos mit deiner ersten Story los!

Leg jetzt kostenlos mit deiner ersten Story los!
Starte kostenlos mit deiner ersten Geschichte – und vielen weiteren!
Während deiner kostenlosen Testphase von 14 Tage kannst du insgesamt 30 Stunden lesen und hören.